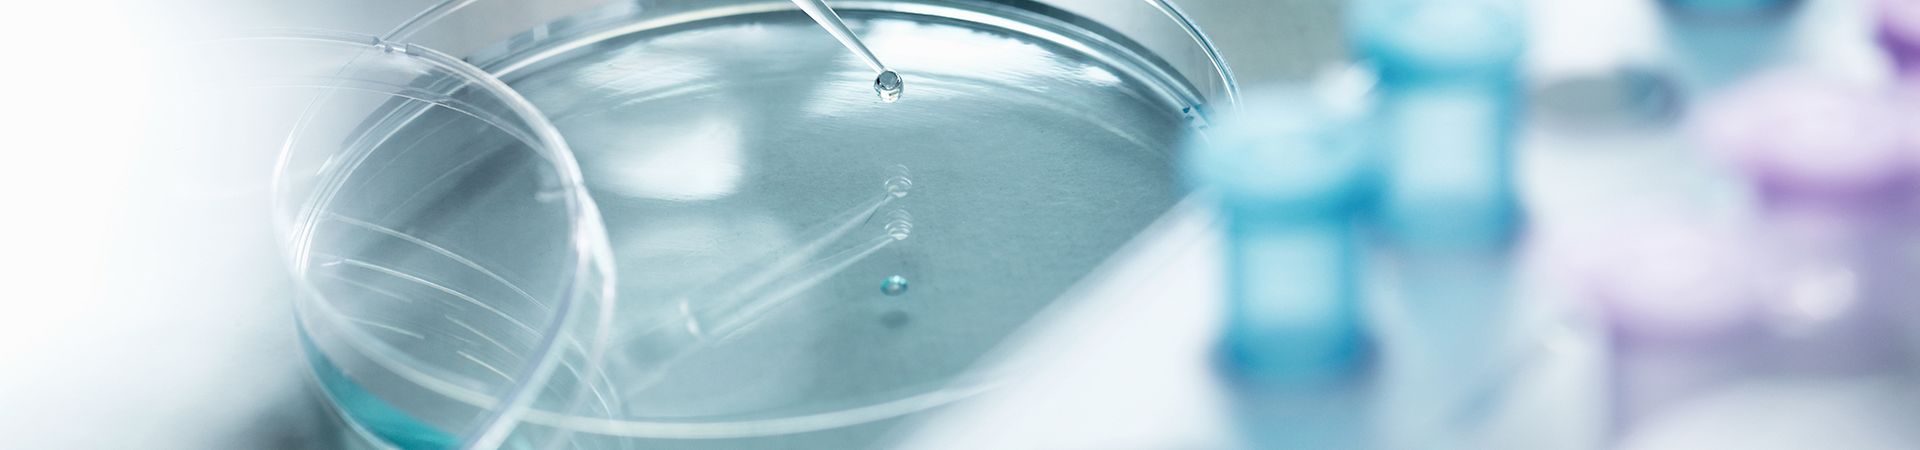

market share of total pharmaceutical market
Your company is already operating in Germany and you would now like to export worldwide?
Key Facts
Germany’s biopharmaceuticals sector outpaced the overall market in Germany with turnover of EUR 23.1 billion in 2024 – a 20.3 percent growth compared to 2023.
Facts & Figures
European Leader
Germany is not only the world’s largest medical biotech nation behind the US but is also the country with the highest medical biotechnology R&D spending in Europe (EUR 4.6 billion in 2024).
Largest IVD Market in Europe
Today, 70 percent of all clinical diagnoses are made using in vitro diagnostics (IVD). With more than EUR 2.4 billion in annual revenue in 2024, Germany represents the largest IVD market in Europe and the second worldwide behind the USA.
Top Biotechnology Hub
With the largest amount of biotech companies in Europe, world-class research infrastructure, and internationally renowned scientists, Germany has firmly established itself as an international medical biotechnology hub.
Opportunities
IVD & Molecular Diagnostics
In-vitro diagnostics (IVDs) are a crucial part of modern medicine: laboratory-based tests performed on biological samples provide information that is key for the prevention, treatment and management of diseases. Today, 70 percent of all clinical diagnoses are made using IVDs. With more than EUR 2.4 billion in annual revenue in 2024, Germany represents the largest IVD market in Europe and the second worldwide behind the USA.
Biopharmaceuticals Market
Big pharmaceutical concerns and smaller biotechnology companies alike are focusing on drug discovery and development of medicines produced by biotechnological processes. Small molecules are moving to the background in medicine development as the result of a major paradigm shift to biopharmaceuticals. This is reflected by the increasing sales of biopharmaceutical products worldwide. According to a report by healthcare research service provider IQVIA, sales of biopharmaceuticals in Germany increased to EUR 23.1 billion in 2024 (growth of 20.3percent compared to 2023). Growth was seen in nearly all fields of application, particularly in drugs treating immunological (e.g. rheumatic) as well as infectious diseases and cancer.
The number of biopharmaceuticals in clinical development increased from 657 in 2020 to 674 in 2024 – reflecting continued high investment in the biopharmaceutical pipeline. In 2024, a record-breaking 64 percent of all new drug approvals were biopharmaceuticals – more than ever before. By the end of 2024, a total of 447 biopharmaceutical drugs were approved for the German market. Divided into pharmacological classes, vaccines and monoclonal antibodies show the way with a combined 40 percent of all approvals.
Business Environment
Business Environment for Germany’s Medical Biotechnology Industry
Innovation Infrastructure
Science and industry need to work together closely in order for innovations to be commercialized successfully. German bioclusters are proving to be important new technology impulse givers in this respect.
Our interactive map provides you with an overview of important Biotechnology Cluster in Germany:

Biopharma in Germany
Germany has enjoyed a reputation as the “world’s pharmacy” for around a century. The legacy continues into the present day with the success of German companies including BioNTech, Boehringer Ingelheim, and Merck – as well as multi-billion investments by leading international companies every year. Germany’s leading position in the biotechnology and pharmaceuticals industry make it a highly attractive location for innovative companies focused on biopharmaceuticals.
Could your company benefit from being part of the biotechnology ecosystem in Europe’s largest economy? Germany Trade & Invest can help – totally free of charge. Get in touch.